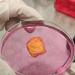
إنجاز إماراتي جديد.. مركز أبوظبي للخلايا الجذعية يطلق علاجاً مبتكراً للسرطان

بروكسل - أ ف ب
أكد حلف شمال الأطلسي (ناتو) الأربعاء أنه أُبلغ مسبقاً بخطة الولايات المتحدة خفض عديد قواتها المنتشرة في بلدانه الشرقية، واصفاً الخطوة بأنها مجرّد «تعديل» للوضع القائم ولا تنطوي على أي أمر «غير عادي».
وقال مسؤول في الناتو «حتى مع هذا التعديل، فإن وجود القوات الأمريكية في أوروبا يبقى أكبر مما كان عليه لسنوات عديدة، مع وجود عدد أكبر بكثير من القوات الأمريكية في القارة مقارنة مع ما كان عليه الحال قبل عام 2022»، مضيفاً أن التزام واشنطن حيال الحلف ما زال «واضحاً».

0 تعليق